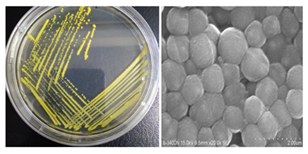
Figure

Current Issue

German Journal of Pharmaceuticals and Biomaterials (GJPB) [ p-ISSN: 2750-624X | e-ISSN:2750-6258 ] is an interdisciplinary peer-reviewed open-access scientific journal, that publishes high-quality experimental and theoretical research that contributes significantly to all aspects of pharmaceutical sciences and biomaterials and their related subjects including their applications in human (covering experimental and clinical therapeutics).